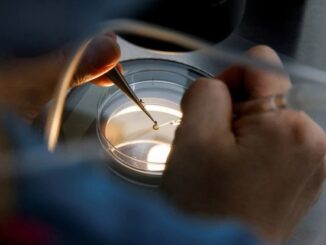

Ukraine nói Nga sắp trưng cầu dân ý ở Mariupol
Giới chức Ukraine cho biết Nga đang chuẩn bị tổ chức một cuộc trưng cầu dân ý ở thành phố cảng miền nam Mariupol về việc sáp nhập vào nước này.

Giới chức Ukraine cho biết Nga đang chuẩn bị tổ chức một cuộc trưng cầu dân ý ở thành phố cảng miền nam Mariupol về việc sáp nhập vào nước này.

Đức cho biết sẵn sàng đẩy nhanh quá trình phê duyệt nếu Phần Lan và Thụy Điển quyết định xin gia nhập NATO.

Thêm 15 trường hợp tử vong và ít nhất 296.180 người bị sốt được báo cáo ngày 15-5, nâng tổng số ca nghi ngờ mắc Covid-19 ở Triều Tiên lên tới 820.620 người.

Sự sụp đổ của một stablecoin từng được ca ngợi “hết lời” đã làm dấy lên những câu hỏi quan trọng về hiệu quả, tiềm năng của toàn bộ thị trường tiền ảo.

Ủy ban Chứng khoán sẽ giao VNX chỉ đạo HNX và HOSE đưa ra các cảnh báo, yêu cầu doanh nghiệp niêm yết công bố thông tin khi các mã chứng khoán có dấu hiệu tăng, giảm giá trần, sàn từ 5 – 10 phiên

Sự tăng trưởng mạnh của nhóm ngân hàng dẫn đến có 4/5 nhà băng Việt Nam góp mặt trong danh sách Global 2000 năm 2022 của Forbes. Cả 5 doanh nghiệp đều có kết quả kinh doanh tăng trưởng giai đoạn 3 năm gần đây.

SGI Capital nhận định rằng “Để thành công lâu dài và hạn chế các tổn thất lớn trên TTCK đầy biến động, NĐT cần tránh làm hai việc là FOMO mua vào khi thị trường và cổ phiếu đã tăng nóng và bán ra cắt lỗ khi danh mục cổ phiếu tốt đã giảm giá rất mạnh về định giá rất rẻ như hiện tại. Còn lại, một danh mục cổ phiếu tốt và rẻ sẽ tự gia tăng giá trị theo thời gian và mang lại lợi nhuận xứng đáng”.

Cuộc chiến tỷ ‘đô’ giữa Amazon và Shopify đang ngày càng nóng lên.

Câu thần chú “không có sự thay thế nào cho cổ phiếu” dường như không còn phát huy tác dụng khi thị trường liên tục giảm sâu, lạm phát và lãi suất tăng với tốc độ nhanh chóng.

Việc Trung Quốc phong toả nhiều địa phương đang khiến chuỗi cung ứng toàn cầu chao đảo và ảnh hưởng của nó bắt đầu gây tác động đến các công ty và người tiêu dùng toàn cầu.

Một đoàn thượng nghị sĩ Mỹ, trong đó có lãnh đạo phe Cộng hòa tại Thượng viện Mitch McConnell, ngày 14/5 đến Kiev, gặp mặt Tổng thống Ukraine Volodymyr Zelensky.

Thổ Nhĩ Kỳ ngày 14/5 đưa ra đề nghị hỗ trợ sơ tán các thương binh Ukraine đang cố thủ tại nhà máy thép Azovstal ở Mariupol bằng đường biển.

Nga phủ nhận sau khi Ukraine tuyên bố tấn công và làm hư hại một tàu hậu cần hiện đại của nước này gần đảo tiền tiêu trên Biển Đen.
Thống kê năm 2021 cho thấy, tỷ lệ sinh ở Hàn Quốc đang ở mức thấp nhất trong lịch sử, theo thông tin từ Cơ quan thống kê của nước này.

Các động thái của EU nhằm “cai” dầu và khí đốt của Nga đang đẩy chính họ vào tình thế khó khăn.

Copyright © 2026 | babfx.com